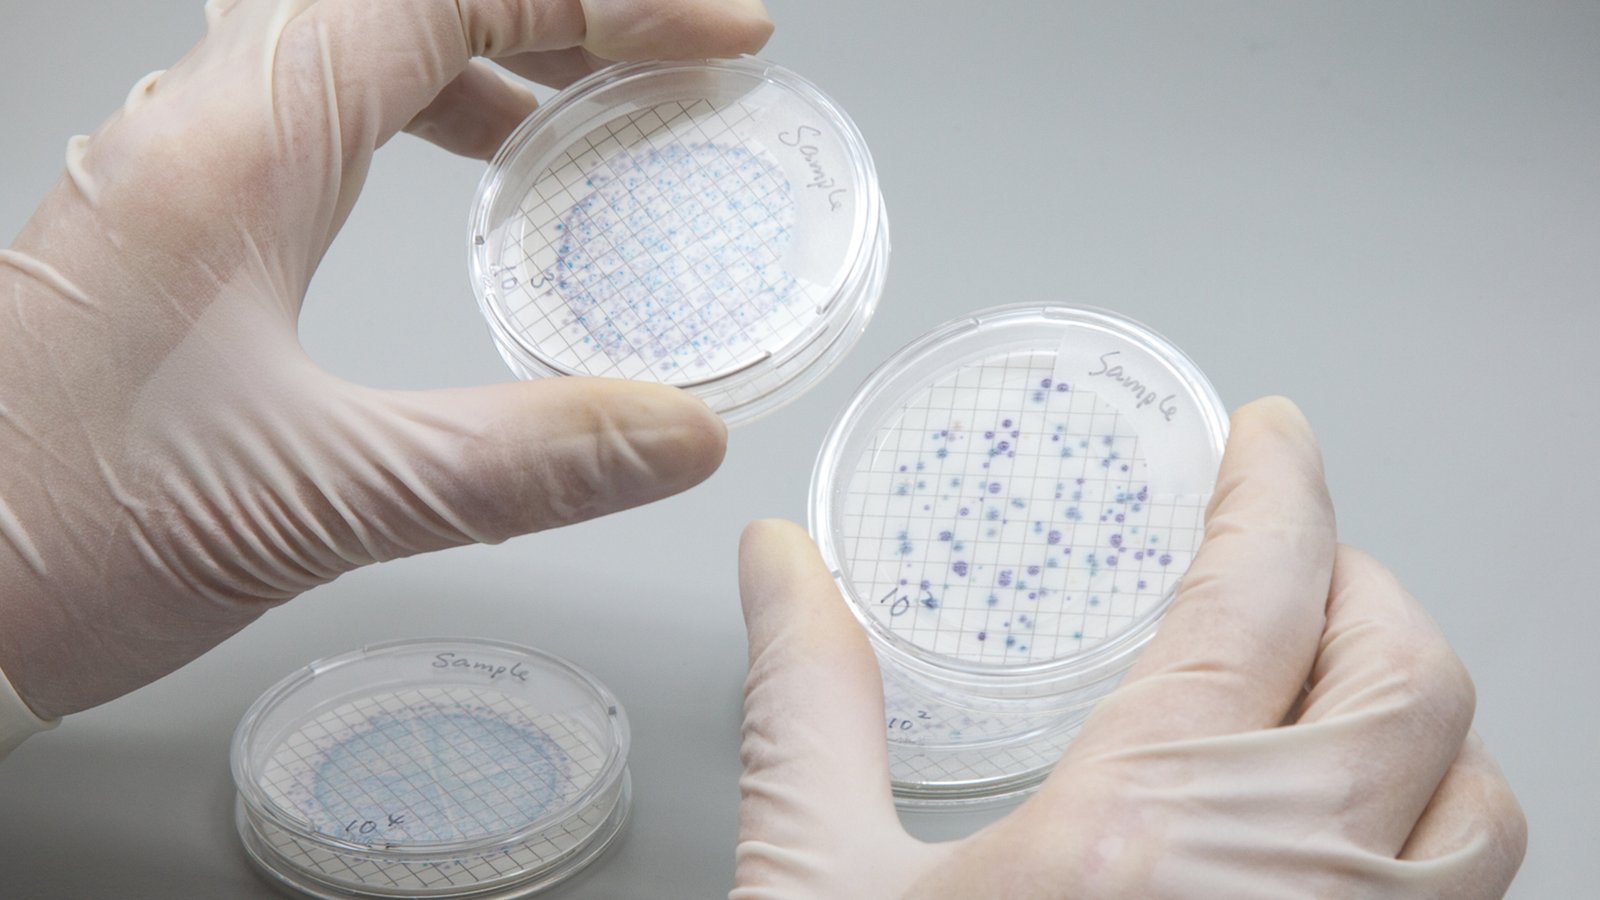
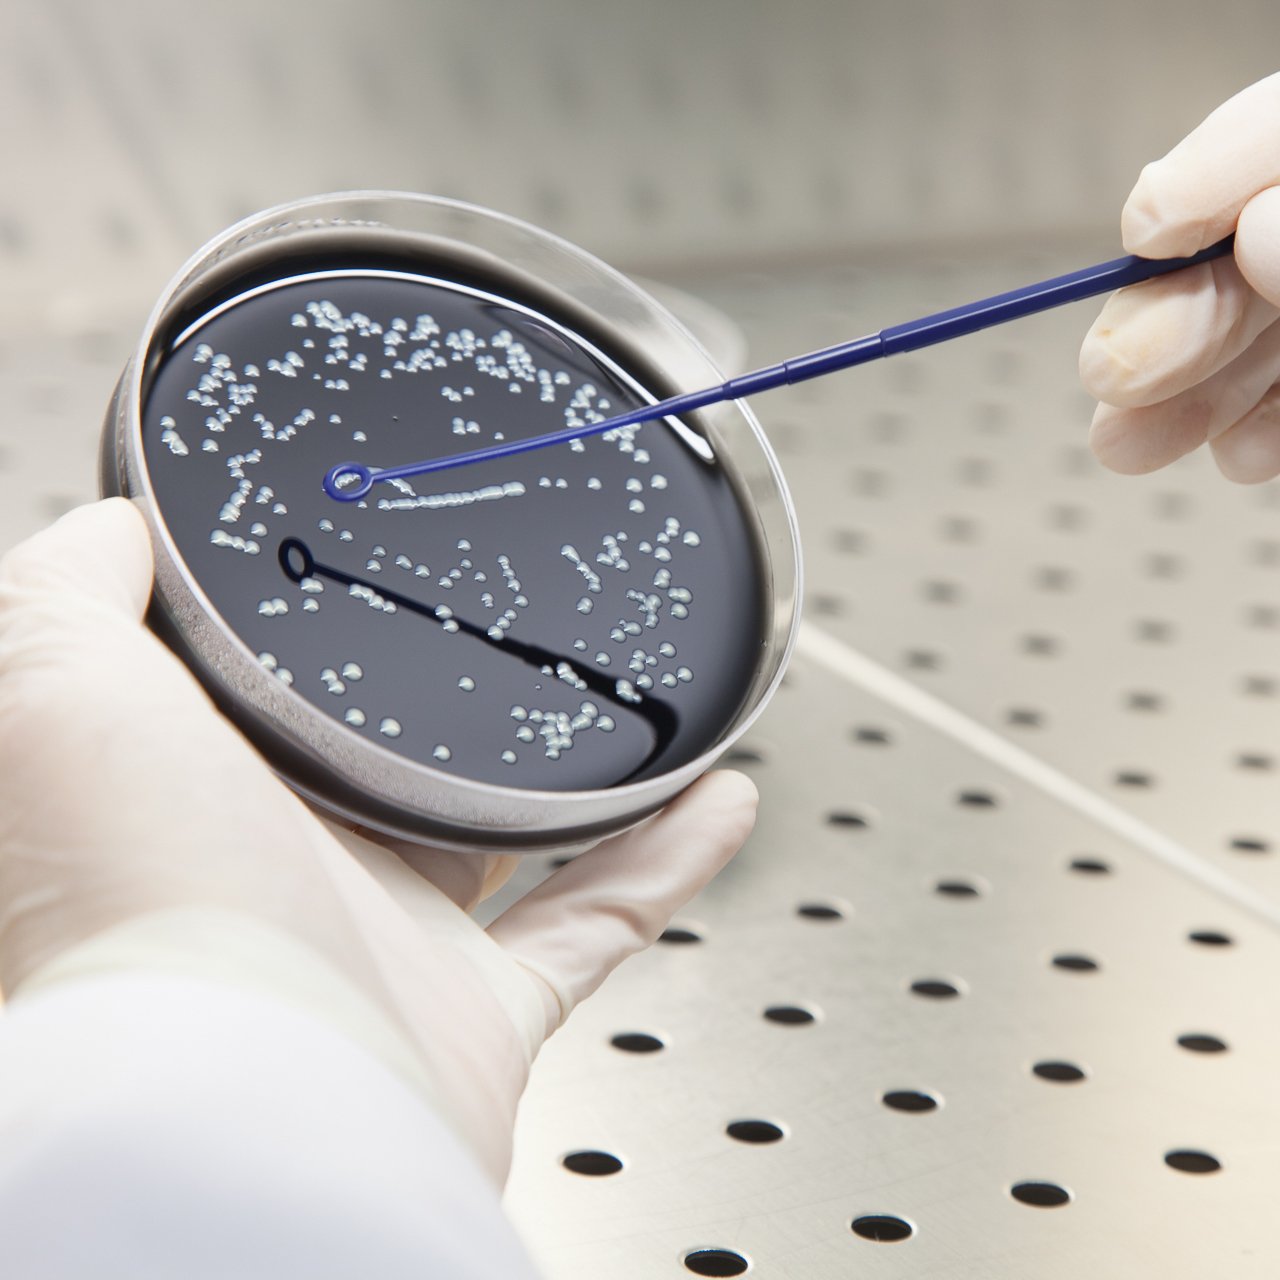

With over 20 years experience in Environmental & Chemical Testing, ETL’s well-equipped laboratories have high-tech instrumentation to provide a full range of independent testing services in Microbiology, Chemical, Environmental and Asbestos, with many analytical techniques accredited by HOKLAS.
In 2015, ETL’s Environmental & Chemical division expanded its range of services by adding a Microbiology section. With its state-of-the-art facilities and instrumentation, our highly-trained professionals provide specialist skills to offer a fully-comprehensive service to our customers.
Our experienced engineers have worked on major projects in Hong Kong such as Hong Kong-Zhuhai-Macao Bridge Hong Kong Boundary Crossing Facilities, MTR Sha Tin to Central Express Rail Link, Replacement and Rehabilitation of Water Mains for the Water Supplies Department on Outlying Islands, Stonecutters Island Sewage Treatment Works and the Central to Wan Chai Bypass. Contact our experts for further details on specific job references.